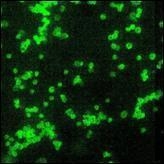

(一)发病原因
本病病原体为鼻疽伯克霍尔德菌(Burkholderia mallei)。曾被称为鼻疽费氏杆菌(1918年)、鼻疽放线杆菌(1933年)、鼻疽不动杆菌(1964年)、鼻疽假单胞菌(1966年)等。1993年,国际上根据新发现本菌的生物学特性,将其列入伯克霍尔德菌属(Burkholderia)。国内常称为鼻疽杆菌。鼻疽杆菌为微弯棒状杆菌,大小不一,长为2~5μm,宽0.5~1.0μm,多单个,有时可成对排列,无鞭毛不能运动,无荚膜,不产生芽孢,为需氧革兰染色阴性菌。温度在37~38℃,pH6.8~7.0时生长最适宜。在普通培养基上本菌生长不佳,但在1%~5%的甘油肉汤中发育良好,在马铃薯培养基上能产生一层淡黄色蜂蜜样菌苔,以后逐渐变为棕红色。本菌生长较缓慢,一般需48h。正常菌落为光滑型(S),变异后的菌落可出现粗糙型(R)、皱襞型(C)、矮小型(D)、黏液型(M)或伪膜型(P)等。
本菌应与类鼻疽伯克霍尔德菌相鉴别。鼻疽杆菌能产生两种抗原,一种是特异性多糖抗原,另一种是与类鼻疽杆菌在凝集试验和皮肤试验均有交叉的共同抗原(蛋白质成分)。
本菌抵抗力较强,在粪、尿中可生存4h,水中生存70天,灭菌的自来水中生存6个月。但在干燥环境中仅生存10~15天,日光直接照射24h或加热56℃ 15min均可死亡,煮沸立即死亡。本菌对化学制剂敏感,在3%煤酚皂溶液、10%石灰乳、2%甲醛中1h即可杀死。
(二)发病机制
本病的作用机制是细菌进入机体,在体内产生内毒素,引起机体发生变态反应。本菌不产生外毒素,其菌体的内毒素——鼻疽菌素能使感染动物产生变态反应。本病主要通过接触传播,病菌可通过破损的皮肤、黏膜、呼吸道、消化道进入人体引起感染。
(三)病理生理
明显的病理改变器官组织是皮肤淋巴管、鼻腔粘膜、肺部。共同的病理变化是结节性溃疡,如皮肤淋巴管形成硬固的念珠状结节,躯干、四肢出现组织溃疡、坏死肉芽肿;鼻腔小米粒至高梁粒大小结节;肺部出现粟粒大小结节。